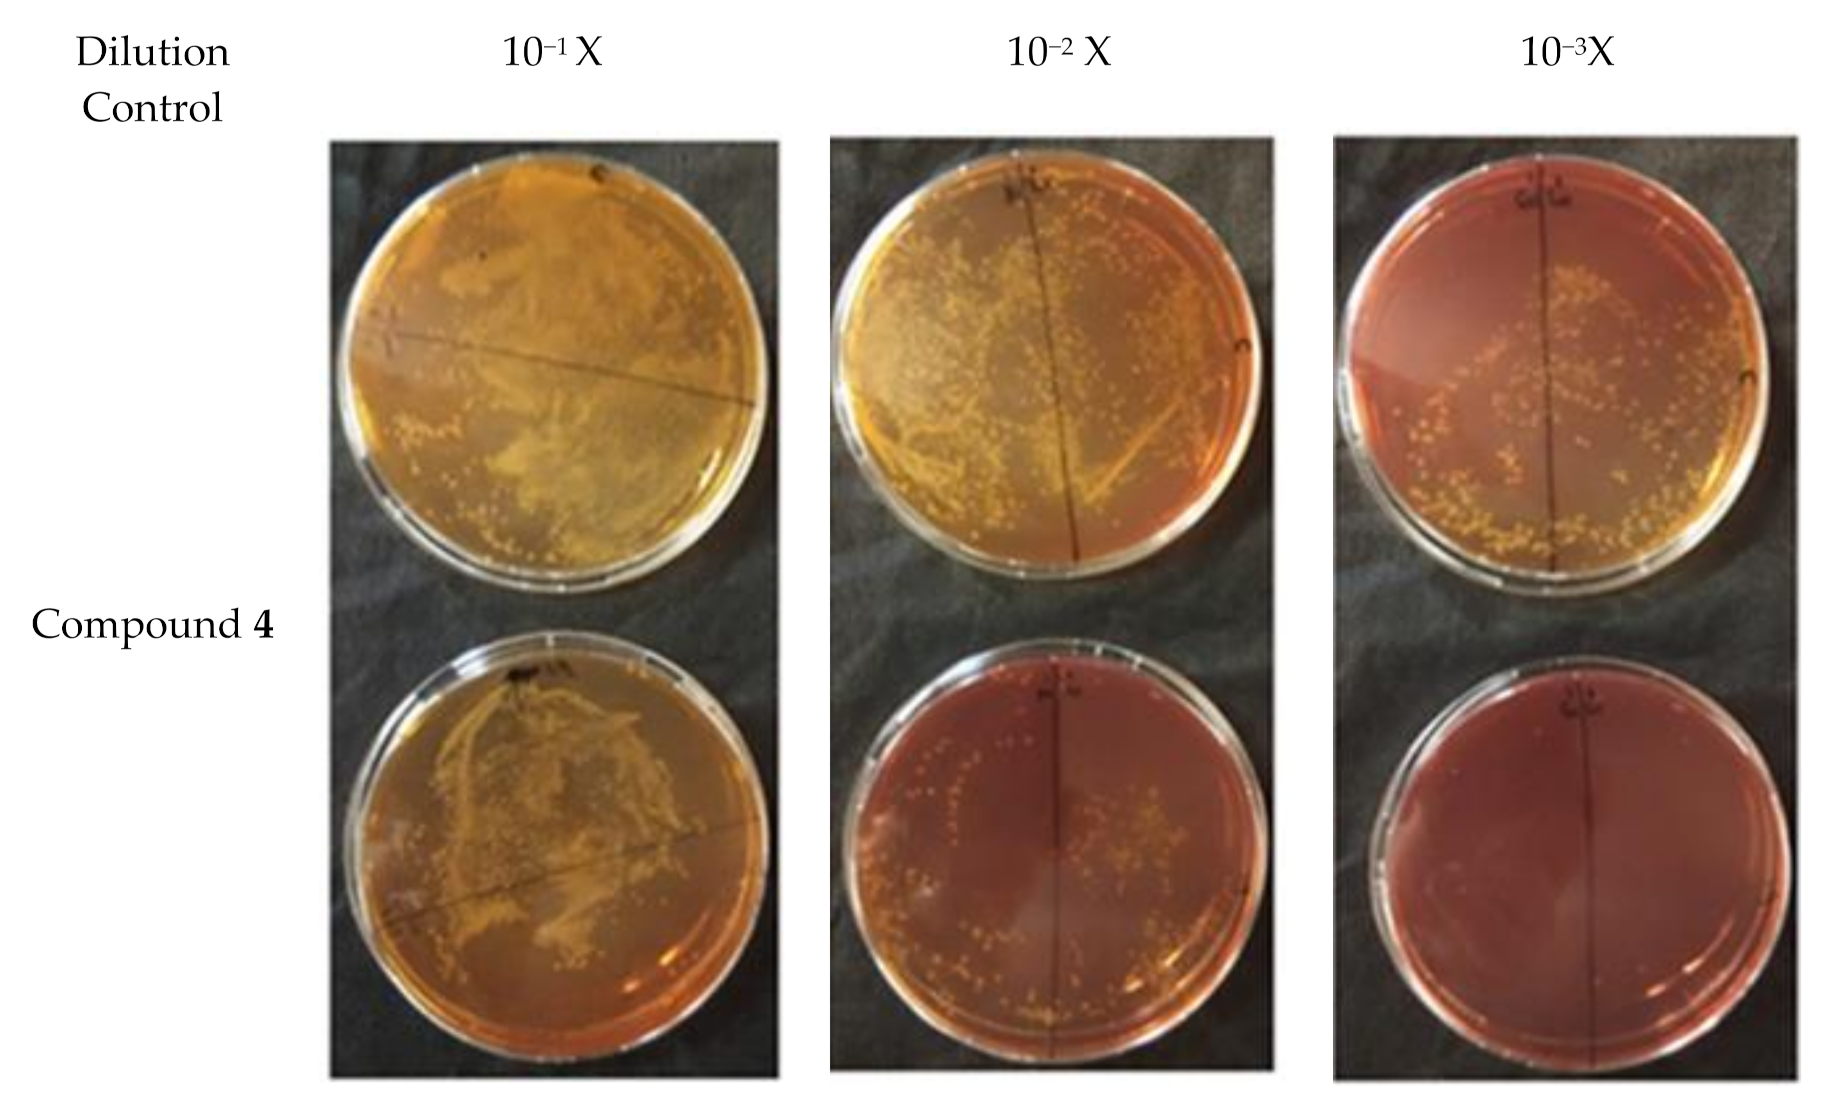
Antibiotics 09 00913 g003 Antibiotics 09 00913 g003

Bioactive Compounds from the Bornean Endemic Plant Goniothalamus longistipetes
Abstract
1. Introduction
2. Results
2.1. Phytochemistry
2.2. Antibacterial Activities
2.3. Drug Accumulation and Inhibition of Biofilm Formation Assays
2.4. Plate Conjugation Assay
3. Discussion
4. Materials and Methods
4.1. General Experimental Procedures
4.2. Plant Materials
4.3. Extraction and Isolation
4.4. Bacterial Strains and Drug Susceptibility Assays
4.5. Eukaryotic Cytotoxicity Assay
4.6. Accumulation Assay
4.7. Biofilm Assay
4.8. Plate Conjugation Assay
4.9. Statistical Analyses
5. Conclusions
Supplementary Materials
Author Contributions
Funding
Acknowledgments
Conflicts of Interest
References
- Newman, D.J.; Cragg, G.M. Natural products as sources of new drugs from 1981–2014. J. Nat. Prod. 2016, 79, 629–661. [Google Scholar] [CrossRef]
- Lewis, W.H.; Elvin-Lewis, M.P. Medicinal plants as sources of new therapeutics. Ann. Missouri Bot. Gard. 1995, 7, 113–118. [Google Scholar] [CrossRef]
- Guzman, J.D.; Gupta, A.; Bucar, F.; Gibbons, S.; Bhakta, S. Antimycobacterials from natural sources: Ancient times, antibiotic era and novel scaffolds. Front Biosci. (Landmark Ed). 2012, 17, 1861–1881. [Google Scholar] [CrossRef] [PubMed]
- Duval, R.E.; Grare, M.; Demoré, B. Fight Against Antimicrobial Resistance: We Always Need New Antibacterials but for Right Bacteria. Molecules 2019, 24, 3152. [Google Scholar] [CrossRef] [PubMed]
- Cowan, M. Plant products as antimicrobial agents. Clin. Microbiol. Rev. 1999, 12, 564–582. [Google Scholar] [CrossRef] [PubMed]
- Chai, P.K. Medicinal Plants of Sarawak; Forest Department Sarawak: Kuching, Malaysia, 2006; p. 212. [Google Scholar]
- Endela, T.; Liam, J.; Sayok, A.K. Tumbuhan Ubatan di Taman Negara Loagan Bunut; PSF Technical Series No. 7. UNDP/GEF; Forest Department Sarawak: Kuching, Malaysia, 2006; p. 91. (In Malay) [Google Scholar]
- Wiart, C. Goniothalamus Species: A source of drugs for the treatment of cancers and bacterial infections? Evid. Based Complement. Alternat. Med. 2007, 4, 299–311. [Google Scholar] [CrossRef] [PubMed]
- Muhammad, S.A.; Muhammad Syarhabil, A.; Awang Soh, M.; Ahmad, M.Z. Goniothalamus: Phytochemical and ethnobotanical review. Recent Adv. Biol. Med. 2016, 2, 34–47. [Google Scholar] [CrossRef]
- Bermejo, A.; Figadiere, B.; Zafra-Polo, M.-C.; Borrachina, I.; Estornell, E.; Cortes, D. Acetogenins from Annonaceae: Recent progress in isolation, synthesis and mechanisms of action. Nat. Prod. Rep. 2005, 22, 269–303. [Google Scholar] [CrossRef]
- Loder, J.W.; Nearn, R.H. Altholactone: A novel tetrahyfrofur[3,2b] pyran-5-one from a Polyathia species. Heterocycles 1997, 7, 113–118. [Google Scholar] [CrossRef]
- Rice, L.B.; Bonomo, R.A. Mechanisms of resistance to antibacterial agents. In Manual of Clinical Microbiology, 9th ed.; Murray, P.R., Ed.; ASM Press: Washington, DC, USA, 2007; pp. 1114–1136. [Google Scholar]
- Momani, F.A.; Alkofahi, A.S.; Mhaidat, N.M. Altholactone displays promising antibacterial activity. Molecules 2011, 16, 4560–4566. [Google Scholar] [CrossRef]
- Khan, M.R.; Komine, K.; Omoloso, A.D. Antimicrobial activity of Goniothalamus grandiflorus. Pharml. Biol. 1999, 37, 340–342. [Google Scholar] [CrossRef]
- Iqbal, E.; Lim, L.B.L.; Kamariah, A.B.; Faizi, S.; Ahmad, A.; Mohamed, A.J. Isolation and characterization of aristolactam alkaloids from the stem bark of Goniothalamus velutinus (Airy Shaw) and their potential as anti-cancer agents. Front. Pharmacol. 2019, 10, 783–800. [Google Scholar] [CrossRef]
- Alav, I.; Sutton, J.M.; Rahman, K.M. Role of bacterial efflux pumps in inhibition of biofilm assay. J. Antimicrob. Chemother. 2018, 73, 2003–2020. [Google Scholar] [CrossRef] [PubMed]
- Kvist, M.; Hancock, V.; Klemm, P. Inactivation of efflux pumps abolishes bacterial inhibition of biofilm assay. Appl. Environ. Microbiol. 2008, 74, 7376–7382. [Google Scholar] [CrossRef] [PubMed]
- Chen, H.; Cao, J.; Zhou, C.; Liu, H.; Zhang, X.; Zhou, T. Biofilm assay restrained by subinhibitory concentrations of Tigecyclinin Acinetobacter baumannii is Associated with Downregulation of Efflux Pumps. Chemotherapy 2017, 62, 128–133. [Google Scholar] [CrossRef] [PubMed]
- Gibbons, S.; Udo, E.E. The effect of reserpine, a modulator of multi-efflux pumps on the in vitro activity of tetracycline against clinical isolates of methicillin resistant Staphylococcus aureus (MRSA) possessing the tet(K) determinant. Phytother. Res. 2000, 14, 139–140. [Google Scholar]
- Kumar, S.; Mukherjee, M.M.; Varela, M.F. Modulation of Bacterial Multidrug Resistance Efflux Pumps of the Major Facilitator Superfamily. Int. J. Bacteriol. 2013, 1–15. [Google Scholar] [CrossRef]
- Langer, P.J.; Walker, G.C. Restriction endonuclease cleavage map of pKM101: Relationship to parental plasmid R46. Mol. Gen. Genet. 1981, 182, 268–272. [Google Scholar] [CrossRef]
- Barr, J.R.; Murthy, V.S.; Yamaguchi, S.; Singh, S.; Smith, D.H.; Hecht, S.M. 5- Alkylresorcinols from Hakea amplexicaulis that cleave DNA. Chem. Res. Toxicol. 1988, 1, 204–207. [Google Scholar] [CrossRef]
- Piddock, I.J.V. Clinically relevant chromosomally encoded multidrug resistance efflux pumps in bacteria. Clin. Microbiol. Rev. 2005, 19, 382–402. [Google Scholar] [CrossRef]
- Fronces, R.; Christie, P.J.; Waksman, G. The structural biology of type IV secretion systems. Rev. Microbiol. 2009, 7, 703–714. [Google Scholar] [CrossRef] [PubMed]
- Sgro, G.G.; Oka, Z.G.L.; Souza, D.P.; Cenens, W.; Bayer-Santos, E.; Matsuyama, B.Y.; Bueno, N.F.; Dos Santos, T.R.; Alvarez-Martinez, C.E.; Matsuyama, B.Y.; et al. Bacteria-killing Type IV Secretion Systems. Front. Microbio. 2019, 10, 1078. [Google Scholar] [CrossRef] [PubMed]
- Carattoli, A. Plasmid-mediated antimicrobial resistance in Salmonella enterica. Curr. Issues Mol. Biol. 2003, 5, 113–122. [Google Scholar] [CrossRef]
- Clewell, D.B. Antibiotic Resistance Plasmids in Bacteria. In eLS; John Wiley & Sons Ltd.: Chichester, UK, 2014; Available online: https://onlinelibrary.wiley.com/doi/abs/10.1002/9780470015902.a0001491.pub3 (accessed on 1 June 2020). [CrossRef]
- Andrews, J.M. Determination of minimum inhibitory concentrations. J. Antimicrob. Chemother. 2001, 48, 5–16. [Google Scholar] [CrossRef] [PubMed]
- Evangelopoulos, D.; Bhakta, S. Rapid methods for testing inhibitors of mycobacterial growth. Methods Mol.Biol. 2010, 642, 193–201. [Google Scholar] [CrossRef]
- Danquah, C.A.; Maitra, A.; Gibbons, S.; Faull, J.; Bhakta, S. HT-SPOTi: A Rapid Drug Susceptibility Test (DST) to Evaluate Antibiotic Resistance Profiles and Novel Chemicals for Anti-Infective Drug Discovery. Curr. Protoc. Microbiol. 2016, 40, 17–18. [Google Scholar] [CrossRef]
- Borra, R.C.; Lotufo, M.A.; Gagioti, S.M.; de Mesquita Barros, F.; Andrade, P.M. A simple method to measure cell viability in proliferation and cytotoxicity assays. Braz. Oral Res. 2009, 23, 255–262. [Google Scholar] [CrossRef]
- Tran, H.T.; Solnier, J.; Pferschy-Wenzig, E.-M.; Kunert, O.; Martin, L.; Bhakta, S.; Huynh, L.; Le, T.M.; Bucar, R.B.B. Antimicrobial and efflux pump inhibitory activity of carvotacetones from Sphaeranthus africanus against Mycobacteria. Antibiotics 2020, 9, 390. [Google Scholar] [CrossRef]
- Stepanović, S.; Vuković, D.; Hola, V.; Bonaventura, G.D.; Djukić, S.; Ćirković, I.; Ruzicka, F. Quantification of biofilm in microtiter plates: Overview of testing conditions and practical recommendations for assessment of biofilm production by staphylococci. APMIS 2007, 115, 891–899. [Google Scholar] [CrossRef]

| 1 | S.I. | 2 | S.I. | 3 | S.I. | 4 | S.I. | |
|---|---|---|---|---|---|---|---|---|
| Gram-positive bacteria | ||||||||
| Staphylococcus aureus | ||||||||
| SA25923 | 64.0 µg/mL (275.7 µM) | 0.49 | 128 µg/mL (551.6 µM) | 3.91 | 128 µg/mL (703.1 µM) | 1.95 | 8 µg/mL (21.4 µM) | 32 |
| SA1199B | 64.0 µg/mL (275.7 µM) | 0.49 | 128 µg/mL (551.6 µM) | 3.91 | 128 µg/mL (703.1 µM) | 1.95 | 8-16 µg/mL (21.4–42.7 µM) | 16 |
| XU212 | 64.0 µg/mL (275.7 µM) | 0.49 | 128 µg/mL (551.6 µM) | 3.91 | 128 µg/mL (703.1 µM) | 1.95 | 8-16 µg/mL (21.4–42.7 µM) | 16 |
| eMRSA-15 | 64.0 µg/mL (275.7 µM) | 0.49 | 128 µg/mL (551.6 µM) | 3.91 | 128 µg/mL (703.1 µM) | 1.95 | 8-16 µg/mL (21.4–42.7 µM) | 16 |
| Bacillus subtilis | 32.0 µg/mL (137.9 µM) | 0.98 | 256 µg/mL (551.6 µM) | 1.95 | 64 µg/mL (363.5 µM) | 3.91 | 8-16 µg/mL (21.4–42.7 µM) | 16 |
| Gram-negative bacteria | ||||||||
| E. coli | 256 (1103.0 µM) | 0.12 | 512 (2206.0 µM) | 0.98 | 256µg/mL (1406.2 µM) | 0.98 | 512 µg/mL (1367.9 µM) | 0.5 |
| Klebsiellapnuemoniae | 256 (1103.0 µM) | 0.12 | 512 (2206.0 µM) | 0.98 | 256 µg/mL (1406.2 µM) | 0.98 | 128 µg/mL (342.0 µM) | 2 |
| Pseudomonas aeruginosa | 500µg/mL (2206.0 µM) | 0.6 | 512µg/mL (2206.0 µM) | 0.98 | 256µg/mL (1406.2 µM) | 0.98 | 128 µg/mL (342.0 µM) | 2 |
| Acid-fast mycobacteria | ||||||||
| Mycobacterium smegmatis | >500 µg/mL (2154.5 µM) | <0.06 | 500 µg/mL (2154.5 µM) | 1 | 500 µg/mL (2154.5 µM) | 0.5 | n.a. | n.a. |
| Mycobacterium bovis BCG | 7.81 µg/mL (33.6 µM) | 4.0 | 500 µg/mL (2154.5 µM) | 1 | 500 µg/mL (2154.5 µM) | 0.5 | 7.8 µg/mL (20.9 µM) | 32 |
| Cell line | ||||||||
| RAW 264.7 macrophage cells | 31.25 µg/mL | 500 µg/mL | 250 µg/mL | 250 µg/mL | ||||
| Donor Strain | Plasmid | Resistance Marker | Recipient Strain | Resistance Marker |
|---|---|---|---|---|
| WP2 | pKM101 | Amoxicillin | ER1793 | Streptomycin |
Publisher’s Note: MDPI stays neutral with regard to jurisdictional claims in published maps and institutional affiliations. |
© 2020 by the authors. Licensee MDPI, Basel, Switzerland. This article is an open access article distributed under the terms and conditions of the Creative Commons Attribution (CC BY) license (http://creativecommons.org/licenses/by/4.0/).
Share and Cite
Teo, S.P.; Bhakta, S.; Stapleton, P.; Gibbons, S. Bioactive Compounds from the Bornean Endemic Plant Goniothalamus longistipetes. Antibiotics 2020, 9, 913. https://doi.org/10.3390/antibiotics9120913
Teo SP, Bhakta S, Stapleton P, Gibbons S. Bioactive Compounds from the Bornean Endemic Plant Goniothalamus longistipetes. Antibiotics. 2020; 9(12):913. https://doi.org/10.3390/antibiotics9120913
Chicago/Turabian StyleTeo, Stephen P., Sanjib Bhakta, Paul Stapleton, and Simon Gibbons. 2020. "Bioactive Compounds from the Bornean Endemic Plant Goniothalamus longistipetes" Antibiotics 9, no. 12: 913. https://doi.org/10.3390/antibiotics9120913
APA StyleTeo, S. P., Bhakta, S., Stapleton, P., & Gibbons, S. (2020). Bioactive Compounds from the Bornean Endemic Plant Goniothalamus longistipetes. Antibiotics, 9(12), 913. https://doi.org/10.3390/antibiotics9120913

